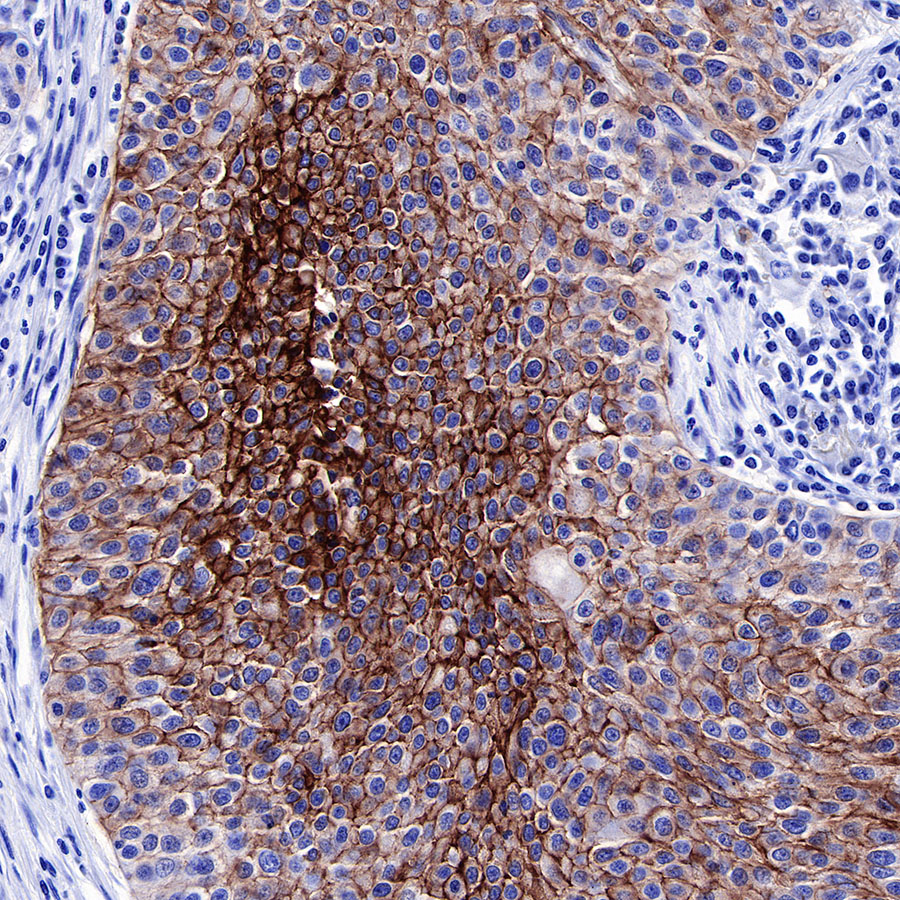
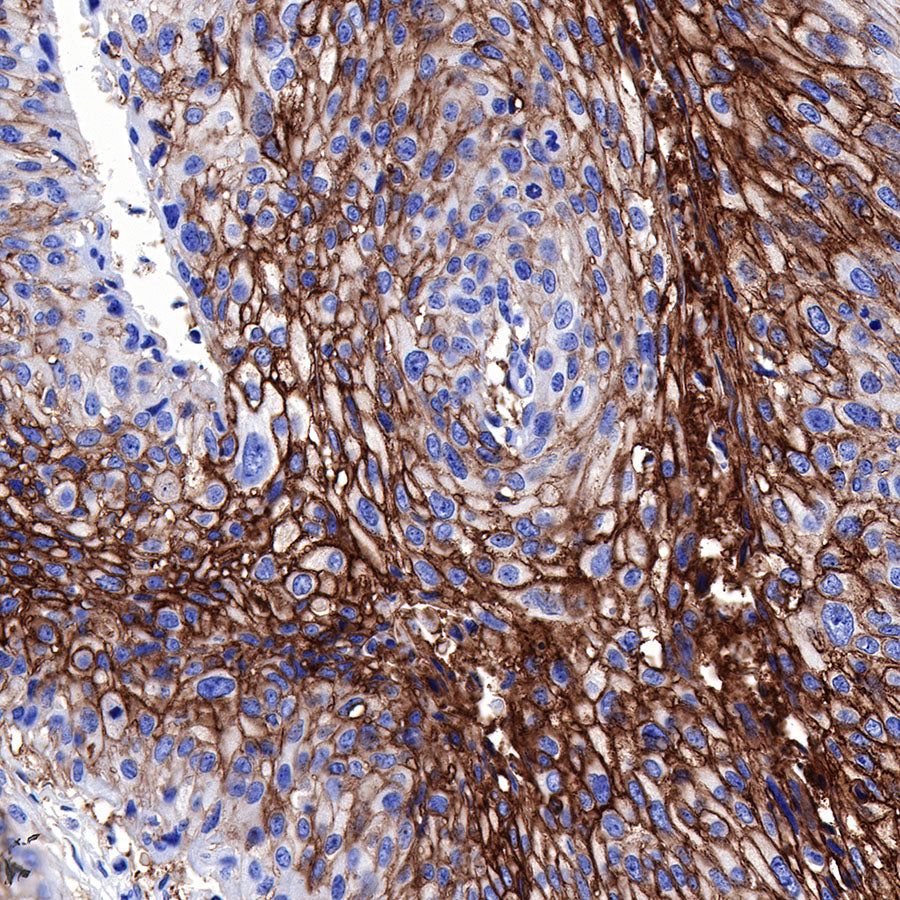

WB result of GLUT1 Rabbit mAb
Primary antibody: GLUT1 Rabbit mAb at 1/10000 dilution
Lane 1: HepG2 whole cell unboiled RIPA lysate 5 µg
Lane 2: SW480 whole cell unboiled RIPA lysate 5 µg
Secondary antibody: Goat Anti-Rabbit IgG, (H+L), HRP conjugated at 1/10000 dilution
Predicted MW: 54 kDa
Observed MW: 45~60 kDa
Exposure time: 180s
Product Details
Product Details
Product Specification
Host | Rabbit |
Antigen | GLUT1 |
Synonyms | SLC2A1 |
Immunogen | Synthetic Peptide |
Location | Cell membrane, Melanosome |
Accession | P11166 |
Clone Number | SDT-047-53 |
Antibody Type | Rabbit mAb |
Application | WB, IHC-P, ICC, ICFCM |
Reactivity | Hu, Ms, Rt |
Predicted Reactivity | Rb, Bv, Pg, Sh |
Purification | Protein A |
Concentration | 0.25 mg/ml |
Physical Appearance | Liquid |
Storage Buffer | PBS, 40% Glycerol, 0.05%BSA, 0.03% Proclin 300 |
Stability & Storage | 12 months from date of receipt / reconstitution, -20 °C as supplied |
Dilution
application | dilution | species |
ICC | 1:500 | |
IHC-P | 1:1000 | |
WB | 1:10000 | |
ICFCM | 1:25 |
Background
Glucose enters cells through various transporters including the GLUT family of facilitative transporters, the sodium/glucose co-transporters, and the recently discovered SWEET family. however, only the role of the GLUT family has been extensively studied in cancer cells. There are 14 GLUT proteins in the human and 12 in the mouse. GLUT1, encoded by SLC2A1, is the predominant transporter overexpressed in tumors, including hepatic, pancreatic, esophageal, brain, renal, lung, cutaneous, colorectal, endometrial, ovarian, cervical, and breast, as well as head and neck tumors.
Picture
Picture
Western Blot

FC

Flow cytometric analysis of 4% PFA fixed 90% methanol permeabilized HT-29 (Human colorectal adenocarcinoma epithelial cell) cells labelling GLUT1 antibody at 1/25 (1 μg) dilution / (red) compared with a Rabbit monoclonal IgG (Black) isotype control and an unlabelled control (cells without incubation with primary antibody and secondary antibody) (Blue). Goat Anti - Rabbit IgG Alexa Fluor® 488 was used as the secondary antibody.
Immunohistochemistry

IHC shows positive staining in paraffin-embedded human cerebral cortex. Anti-GLUT1 antibody was used at 1/1000 dilution, followed by a HRP Polymer for Mouse & Rabbit IgG (ready to use). Counterstained with hematoxylin. Heat mediated antigen retrieval with Tris/EDTA buffer pH9.0 was performed before commencing with IHC staining protocol.

IHC shows positive staining in paraffin-embedded human cervial carcinoma. Anti-GLUT1 antibody was used at 1/1000 dilution, followed by a HRP Polymer for Mouse & Rabbit IgG (ready to use). Counterstained with hematoxylin. Heat mediated antigen retrieval with Tris/EDTA buffer pH9.0 was performed before commencing with IHC staining protocol.

IHC shows positive staining in paraffin-embedded human lung. Anti-GLUT1 antibody was used at 1/1000 dilution, followed by a HRP Polymer for Mouse & Rabbit IgG (ready to use). Counterstained with hematoxylin. Heat mediated antigen retrieval with Tris/EDTA buffer pH9.0 was performed before commencing with IHC staining protocol.

IHC shows positive staining in paraffin-embedded human ovarian carcinoma. Anti-GLUT1 antibody was used at 1/1000 dilution, followed by a HRP Polymer for Mouse & Rabbit IgG (ready to use). Counterstained with hematoxylin. Heat mediated antigen retrieval with Tris/EDTA buffer pH9.0 was performed before commencing with IHC staining protocol.

IHC shows positive staining in paraffin-embedded human placenta. Anti-GLUT1 antibody was used at 1/1000 dilution, followed by a HRP Polymer for Mouse & Rabbit IgG (ready to use). Counterstained with hematoxylin. Heat mediated antigen retrieval with Tris/EDTA buffer pH9.0 was performed before commencing with IHC staining protocol.
IHC shows positive staining in paraffin-embedded human lung cancer. Anti-GLUT1 antibody was used at 1/1000 dilution, followed by a HRP Polymer for Mouse & Rabbit IgG (ready to use). Counterstained with hematoxylin. Heat mediated antigen retrieval with Tris/EDTA buffer pH9.0 was performed before commencing with IHC staining protocol.

IHC shows positive staining in paraffin-embedded mouse cerebral cortex. Anti-GLUT1 antibody was used at 1/1000 dilution, followed by a HRP Polymer for Mouse & Rabbit IgG (ready to use). Counterstained with hematoxylin. Heat mediated antigen retrieval with Tris/EDTA buffer pH9.0 was performed before commencing with IHC staining protocol.

IHC shows positive staining in paraffin-embedded rat cerebral cortex. Anti-GLUT1 antibody was used at 1/1000 dilution, followed by a HRP Polymer for Mouse & Rabbit IgG (ready to use). Counterstained with hematoxylin. Heat mediated antigen retrieval with Tris/EDTA buffer pH9.0 was performed before commencing with IHC staining protocol.
Immunocytochemistry

ICC shows positive staining in HepG2 cells. Anti-GLUT1 antibody was used at 1/500 dilution and incubated overnight at 4°C. Goat polyclonal Antibody to Rabbit IgG - H&L (Alexa Fluor® 488) was used as secondary antibody at 1/1000 dilution.The cells were fixed with 100% ice-cold methanol and permeabilized with 0.1% PBS-Triton X-100. Nuclei were counterstained with DAPI.